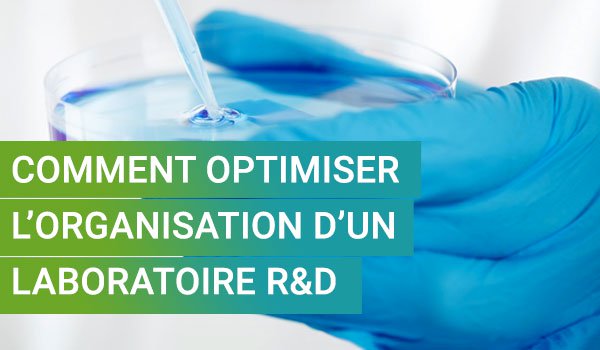
Comment intégrer dans un labo R&amp;D la totalité des tâches en relation avec un procédé:  préparation et l’enregistrement des ingrédients des milieux de culture, programmation des recettes, intégration d’un plan d’expérience, etc ? #LucullusPIMS #bioprocedes 
bit.ly/324wHlc

System-c bioprocess
@system_c_bio
System-c bioprocess propose depuis 20 ans des solutions et technologies pour les procédés de culture cellulaire et de fermentation.
ID: 2512789428
http://www.system-c-bioprocess.com 21-05-2014 14:52:01
58 Tweet
27 Followers
17 Following